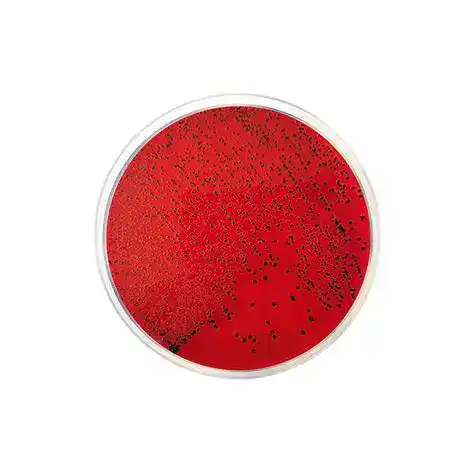
Xylose Lysine Desoxycholate Agar

Tidak ada produk di keranjang.
ANALISIS, BAHAN HABIS PAKAI, BIOSAINS
XYLOSE LYSINE DESOXYCHOLATE AGAR
Xylose Lysine Desoxycholate Agar (XLD Agar) adalah media selektif untuk isolasi Salmonella dan Shigella dalam uji mikrobiologi.
Dalam bidang mikrobiologi, pemilihan media yang tepat menjadi kunci dalam mengidentifikasi bakteri patogen. Salah satu media yang sering dipakai dalam laboratorium adalah Xylose Lysine Desoxycholate Agar (XLD Agar). Media ini dirancang secara khusus untuk mendeteksi serta membedakan bakteri enterik patogen, terutama Salmonella dan Shigella. Dengan formulasi uniknya, XLD Agar membantu peneliti maupun analis laboratorium memperoleh hasil yang akurat.
APA ITU XYLOSE LYSINE DESOXYCHOLATE AGAR?
XLD Agar merupakan media kultur selektif dan diferensial yang digunakan untuk isolasi serta identifikasi bakteri Gram negatif enterik, khususnya Salmonella dan Shigella. Media ini mengandung komponen penting seperti:
- Xylose: dimanfaatkan sebagian besar enterobacteriaceae kecuali Shigella.
- Lysine: memungkinkan deteksi dekarboksilasi yang membedakan Salmonella dari bakteri lain.
- Desoxycholate: berfungsi sebagai agen selektif yang menghambat pertumbuhan bakteri Gram positif.
- Indikator pH (fenol red): membantu mengamati perubahan warna akibat fermentasi.
Kombinasi bahan ini menjadikan XLD Agar sangat efektif dalam mengisolasi serta membedakan bakteri patogen enterik.
APA SAJA KEGUNAANNYA?
XLD Agar memiliki peran penting dalam pemeriksaan mikrobiologi, di antaranya:
- Isolasi Salmonella dan Shigella dari sampel klinis, makanan, maupun lingkungan.
- Membedakan kemampuan fermentasi bakteri enterik berdasarkan penggunaan karbohidrat.
- Mengidentifikasi dekarboksilasi lisin, proses khas yang ditunjukkan oleh Salmonella.
- Menyediakan hasil visual yang jelas melalui perubahan warna koloni, sehingga memudahkan analisis.
Baca juga: Prinsip Kerja Butlerbot W3
BAGAIMANA CARA MENGGUNAKANNYA?
Agar hasil pemeriksaan optimal, penggunaan XLD Agar perlu mengikuti prosedur yang benar. Berikut langkah-langkahnya:
Persiapan Media
- Larutkan bubuk XLD Agar sesuai instruksi produsen dalam air suling.
- Panaskan hingga mendidih sambil diaduk sampai larut sempurna.
- Sterilisasi media dengan autoklaf pada suhu 121°C selama 15 menit.
- Tuangkan ke cawan Petri steril dan biarkan memadat pada suhu ruang.
Inokulasi Sampel
- Ambil sampel yang telah melalui proses (misalnya dari feses, makanan, atau lingkungan).
- Goreskan sampel secara aseptik pada permukaan media dengan metode streak plate.
Inkubasi
Inkubasi cawan pada suhu 35–37°C selama 18–24 jam.
Interpretasi Hasil
- Salmonella: koloni merah dengan pusat hitam akibat produksi H2S.
- Shigella: koloni merah tanpa fermentasi.
- Bakteri fermentatif lain: koloni kuning akibat fermentasi karbohidrat.
Xylose Lysine Desoxycholate Agar (XLD Agar) merupakan media kultur selektif yang sangat berguna dalam mengisolasi serta mengidentifikasi Salmonella dan Shigella. Dengan formulasi khusus yang menggabungkan xylose, lysine, dan desoxycholate, media ini mampu memberikan hasil yang jelas dan akurat. Oleh karena itu, penggunaan XLD Agar sangat direkomendasikan dalam pemeriksaan mikrobiologi baik di bidang klinis, pangan, maupun lingkungan.
Sumber: